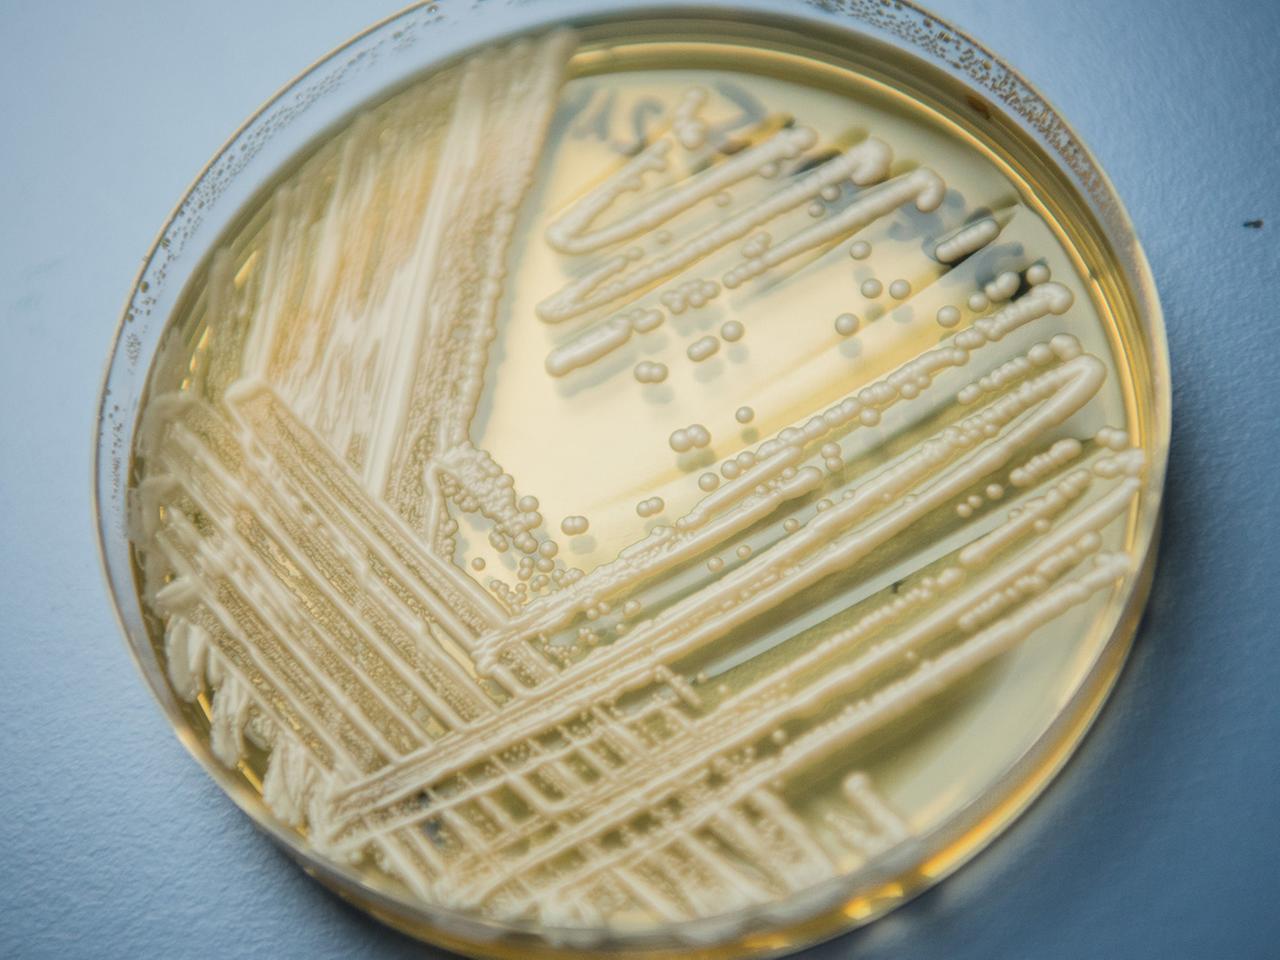

Ciuperca patogenă Candidozyma auris se răspândeşte rapid în spitalele din Europa,conform unui raport publicat de Centrul European pentru Prevenirea şi Controlul Bolilor (ECDC), informează DPA, potrivit stiripesurse.ro.
“Cinci ţări – Spania, Grecia, Italia, România şi Germania – au concentrat majoritatea cazurilor înregistrate în ultimul deceniu”, a precizat ECDC într-un comunicat.
Citeşte şi: Un afacerist moldovean este implicat într-un MEGA-scandal de corupție în România – Stiripesurse.md
Candidozyma auris – cunoscută anterior sub numele de Candida auris – este o ciupercă de tip drojdie, identificată pentru prima dată în Japonia în 2009. De atunci s-a răspândit în mai multe regiuni ale lumii, în special în spitale.
Ciuperca este rezistentă la multiple medicamente şi poate provoca infecţii grave la pacienţii vulnerabili. Capacitatea sa de a supravieţui pe diverse suprafeţe şi dispozitive medicale şi de a se transmite de la o persoană la alta prin aşa-numitele infecţii de contact o face deosebit de dificil de controlat, a subliniat ECDC în raport.
Spre deosebire de coronavirus însă, agentul patogen nu se transmite prin aer.
Creştere a numărului de cazuri raportate în ultimii ani
Studiul autorităţii sanitare arată o creştere rapidă a cazurilor de infecţie cu această ciupercă în UE şi în Spaţiul Economic European.
Între 2013 şi 2023 au fost consemnate în regiune peste 4.000 de cazuri – dintre care 1.346 doar în 2023.
ECDC notează în raport că aceste cifre reprezintă doar “vârful aisbergului”, deoarece numeroase ţări nu înregistrează sistematic cazurile de infecţie cu această ciupercă.
Potrivit UE, eforturile naţionale de depistare, monitorizare şi implementare rapidă a măsurilor de limitare a răspândirii Candidozyma auris ar putea reduce impactul asupra pacienţilor din spitalele europene.